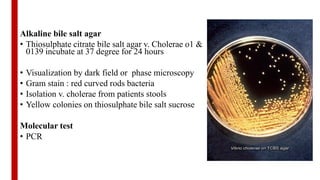
Alkaline bile salt agar
• Thiosulphate citrate bile salt agar v. Cholerae o1 &
0139 incubate at 37 degree for 24 hours
• Visualization by dark field or phase microscopy
• Gram stain : red curved rods bacteria
• Isolation v. cholerae from patients stools
• Yellow colonies on thiosulphate bile salt sucrose
Molecular test
• PCR

The document presents a detailed overview of Vibrio cholerae, the bacterium responsible for cholera, outlining its pathogenicity, transmission modes, symptoms, and clinical implications. It discusses the bacterium's historical significance, virulence factors, and preventive strategies, as well as diagnosis techniques for cholera. The document emphasizes the importance of public hygiene and safe drinking water in combating this disease, particularly in developing and underdeveloped regions.